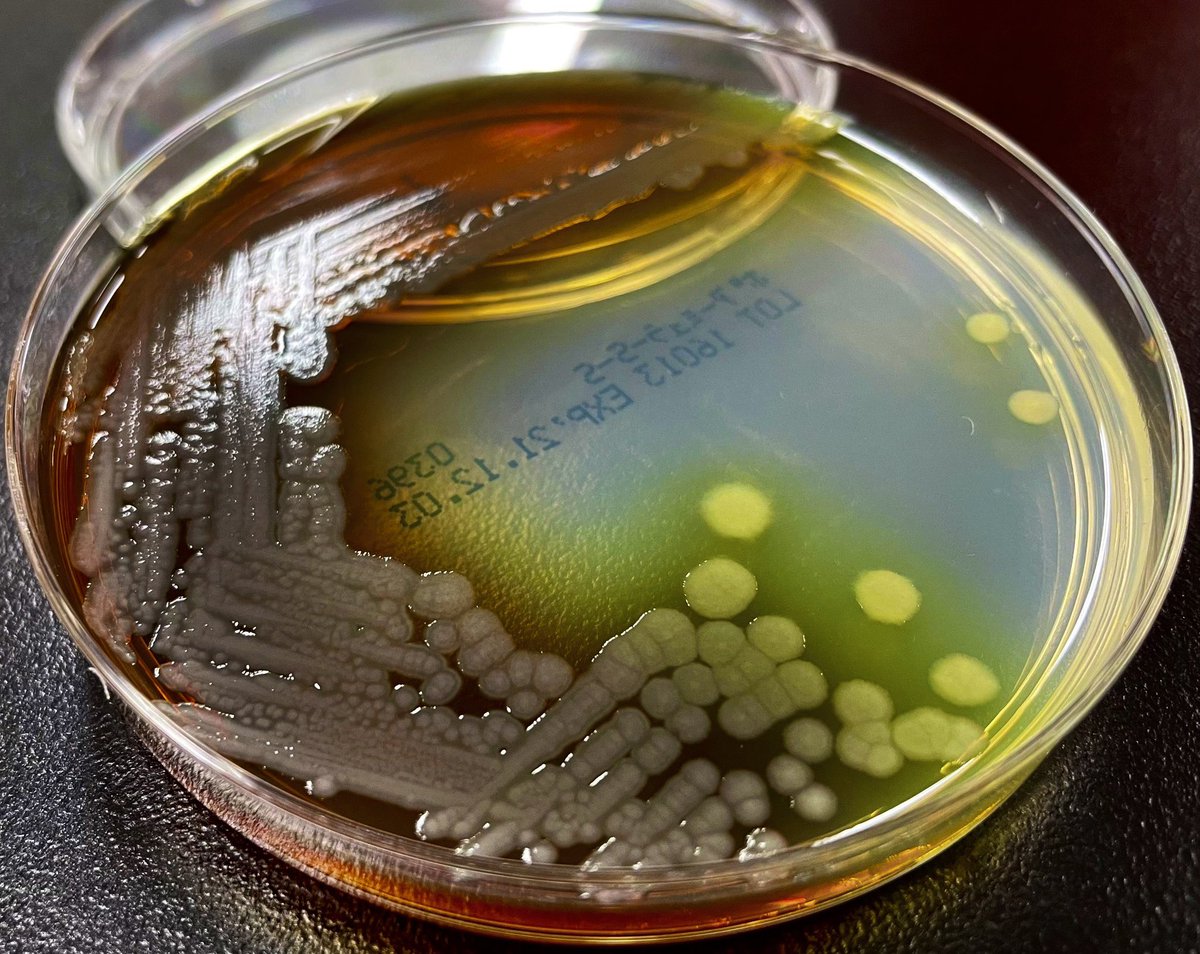
Pseudomonas aeruginosa...🔥🔥

A. Yamid Bolaños
@micro_science8
Candidate for a Master's Degree in Research in Molecular, Cellular and Genetic Biology
ID: 1390150003
29-04-2013 18:19:55
746 Tweet
144 Followers
418 Following

Eps S.O.S - Servicio Occidental de Salud no autoriza una cirugia para mi madre que ingreso desde las 9am a la clínica imbanaco en cali. Quien regula a estas empresas? Supersalud Gustavo Petro Alejandro Ocampo Alexander López Maya










#RevisionSistematica de la literatura en Clinical Infectious Diseases de 56 ensayos clínicos randomizados donde #bactericidas NO mejores q #bacteriostaticos y otros factores (dosis óptima, farmacocinetica. penetracion en tejidos) podrían ser más importantes 📖👉🏻academic.oup.com/cid/article/66…



Me encanta contar la historia de Esther Lederberg en los eventos Día Mujer y Ciencia 👏🏻 Esta grandísima microbióloga revolucionó la genética bacteriana 🦠🧬 A pesar de ello no ganó el Premio Nobel que sí fue concedido… (oh, sorpresa)… a su marido 😟